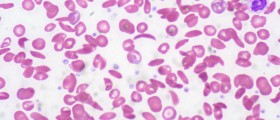

Hi, I would like to know what are characteristics of hairy cell leucemia? How it differs from other sorts of leukemia?
Loading...
Hairy Cell Leukemia is a chronic lymphocytic leukemia (CLL), with slow progression. in this way it is easier to deal with, compared to some other rapid leukemias. It’s strange name originates that from the abnormally shaped lymphocytic white blood cells, of hair-like structure. It affects adults between the ages of 40 to 70.Bone marrow biopsy is needed to have it diagnosed. In some cases enlarged spleen can be noticed. As production of normal blood cells decreases anemia (deficiency of red blood cells), increased susceptibility to infections (deficiency of white blood cells) and lack of blood clotting (insufficiency in platelets).
Loading...